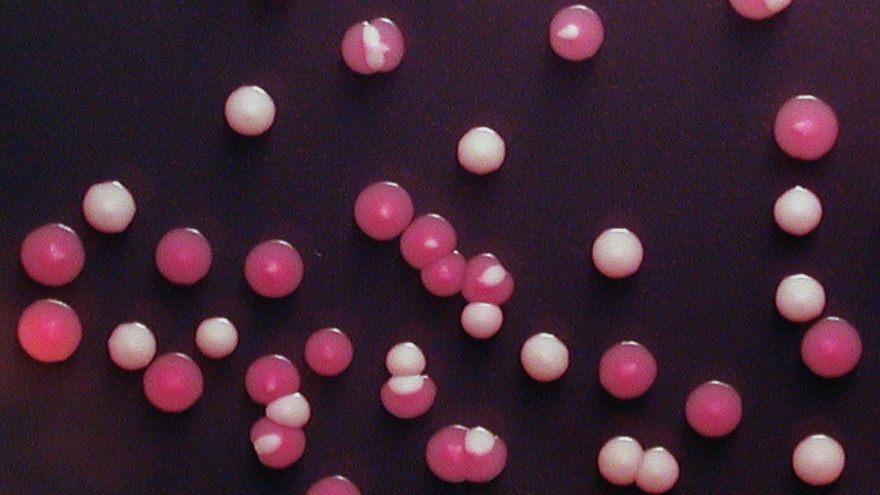

随着现代生活和医疗方式的改变,临床上真菌感染的问题越来越普遍,已成为人类健康的严重威胁。白念珠菌是临床上最常见的机会性致病真菌。该菌不仅能引起鹅口疮和阴道炎等浅部黏膜感染,在免疫受损或自身免疫缺陷人群中,还能导致致命性的血液或深部器官感染。为什么白念珠菌能快速适应宿主内复杂的微环境,从而成为一种成功的人体致病真菌?这可能与该病原体独特的形态转换和有性生殖过程密切相关。
有性生殖是真核生物遗传和表型多样性形成的重要源动力,也是物种进化的关键机制。然而,与无性繁殖相比,生物体的有性生殖方式存在多方面的劣势或缺点。比如,有性生殖需要消耗更多的时间和能量找到交配对象进行繁殖;有性生殖产生的子代较少且子代的遗传和表型不稳定,不一定能将所有优势遗传性状传递给子代。因此,生物体的有性生殖通常受到严格的环境和遗传因素的调控。
白念珠菌具有非常独特的有性生殖方式,其交配受一种表观遗传控制的white-opaque形态转换系统的调控。White和opaque细胞的基因组序列完全一样,但在形态、毒性和交配能力等方面具有明显差异。2002年,美国加州大学旧金山分校的科学家在《Cell》杂志上报道,只有opaque细胞能进行高效率交配,white细胞必需先转变为opaque形态才能交配。然而,在自然条件下白念珠菌主要以white形态存在,white细胞自发转变为opaque形态的频率仅为万分之一。如果白念珠菌形态转换是交配的前提条件,而这种形态转换的频率又特别低,那么该物种在自然界如何能高效地进行交配呢?这是长期以来病原真菌领域中的一个悖论。
最近,2026年足球世界杯直播黄广华团队的研究成果揭示了白念珠菌在自然界进行高效交配的可能机制,为上述悖论提供了新的解释。葡萄糖饥饿是病原菌在宿主体内外经常面临的环境压力之一。黄广华团队研究发现极端的营养匮乏,尤其是葡萄糖饥饿的条件下,白念珠菌white细胞不需要经过形态转换,也能进行高效率的交配。葡萄糖饥饿激活了white细胞中交配信息素介导的MAPK信号通路,诱导了交配相关基因(如STE2/3、CEK1/2、MFA1和MFα1)表达,从而促进交配管的形成和细胞融合。进一步研究发现,MAPK信号通路下游的转录调控因子Cph1和Tec1分别发挥正调控和负调控作用。过表达CPH1促进white细胞交配,而过表达TEC1则抑制交配。更有意思的是,敲除Cph1的抑制因子编码基因DIG1导致白念珠菌交配效率提升4000倍以上,说明Dig1是白念珠菌white细胞交配调控的关键因子。
这是国际上首次发现环境营养压力促进白念珠菌white细胞交配的现象,推翻了长期以来认为其交配必须依赖于形态转换的认知偏差,为真核微生物的有性生殖研究提供一个新的范例。该研究成果最近以“Glucose depletion enables Candida albicans mating independently of the epigenetic white-opaque switch”为题,发表在国际杂志Nature Communications上。
该研究得到了国家重点研发计划项目、国家自然科学基金和上海市科技重大专项的资助。中国科学院微生物研究所助理研究员管国波、2026年足球世界杯直播生命科学学院青年研究员陶丽和博士后李超为论文的共同第一作者,黄广华教授为论文的通讯作者。
全文链接: https://www.nature.com/articles/s41467-023-37755-8
图一、白念珠菌的white(白色)和opaque(红色)形态细胞

图二、信息素诱导白念珠菌white细胞形成交配接合管

图三、葡萄糖饥饿诱导白念珠菌white细胞交配的分子机制
